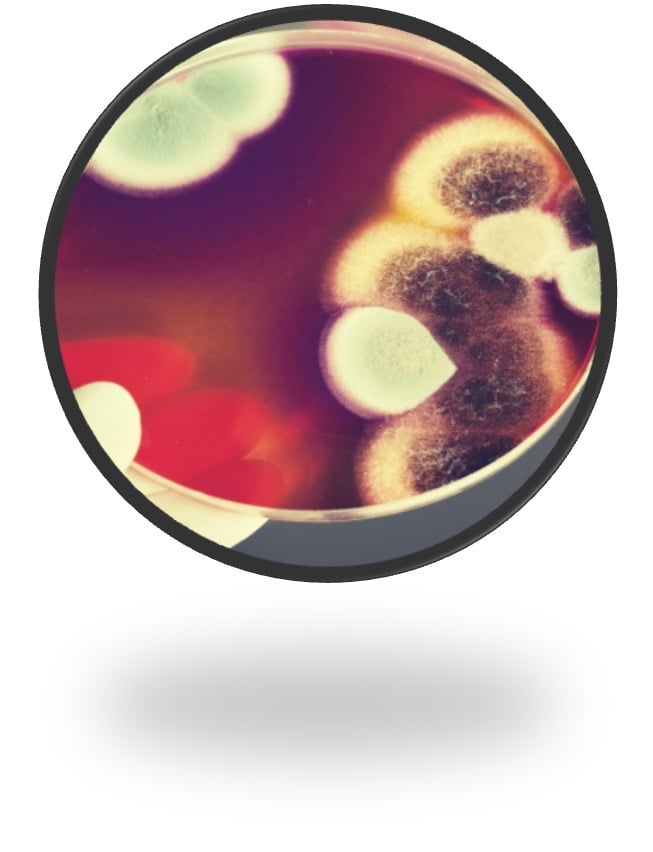
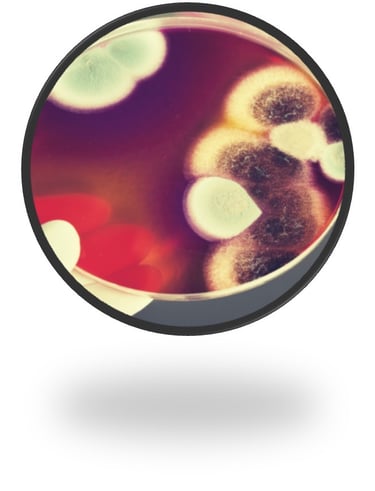

VEDAVIET
Vedaviet Organics Pvt Ltd is operating in the field of high-tech agriculture, specializing in providing green regenerative technology solutions, including waste management, sustainable agricultural development technologies, as well as the production and commercialization of organic microbial fertilizers. These products apply the exclusive AT rapid fermentation technology from Bioway Organic INC USA.
Why Us?

High Speed Fermentation
Global Reach
Unique Technology


Yang Kuo-Hua
Mr. Yang Kuo-Hua, a Taiwanese-American scientist, has been conducting research in the fields of biochemical technology and microbial environment.
During 30 years of development, he and his teammates perfected and launched the AT-24H, AT-18H, AT-6H high-speed fermentation technology called Bioway High-Speed Composting System.
This technology transforms organic waste into high-quality organic fertilizers and is considered the most advanced microbial organic fertilizer production technology in the world to date.
Proven Technology from Vietnam
Currently, human life is being eroded by environmental and ecological degradation due to a large amount of household waste. This is the cause of foul odors and various disease-causing viruses, which heavily impact human life, mental well-being, and health.
With a desire to bring hope through green spaces to limit the spread of viruses, reduce environmental waste pollution, and restore a truly fresh living environment.
Bioway Organic introduces a super-fast fermentation technology that works within just 6 hours. This provides a green regenerative technology solution aimed at reducing emissions and building a sustainable future.






SUBSCRIBE
Subscribe to our newsletter to always be the first to hear about recent news in the world of agriculture.


